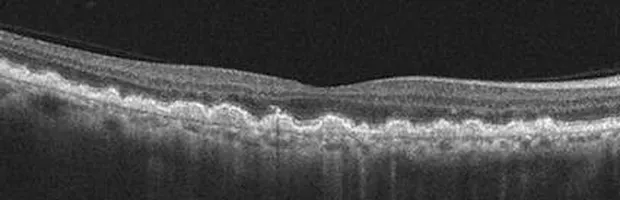
Macular edema

Optical Coherence Tomography (OCT) is an imaging technique that provides unprecedented high resolution and cross-sectional images of the eye. The OCT scan allows micro-structures of the eye to be imaged and shows different color-coded layers of the retina. It is particularly useful in the diagnosis and management of eye conditions such as vitreo-macular traction, macular hole, diabetic macular edema, age-related macular degeneration, epiretinal membrane, and glaucoma.
The normal macula is flat but with a slight dip at very center (known as the fovea). The deepest layer of the retina, the retinal pigmented epithelium (RPE) is smooth and even (orange band).
As people age, the vitreous gel often eventually pulls away from the retina. This posterior vitreous detachment (PVD) is a common cause of new floaters or flashes of light. These symptoms can mimic retinal tear and/or detachment, so a prompt appointment is recommended if ever encountered, in order to rule out those conditions. Typically there is a clean separation of the vitreous membrane and the retina at the time of PVD, but in this photo above there has remained an area of persistent vitreo-macular traction (VMT). This will cause decreased/distorted vision until it releases. When it does release the vision may return to near normal levels, or in some cases it will proceed to the formation of a macular hole (See photo below).
Macular holes can be devastating to central vision. Peripheral vision remains intact, but peripheral vision is just not sensitive to perform visually demanding tasks. This can be repaired by surgery with a vitreo-retinal specialist, although vision is typically still reduced to some degree afterwards.
Macular edema is a potential consequence of diabetic retinopathy. It is the leading cause of decreased visual acuity in diabetes. However, tractional retinal detachments are the leading cause of blindness and permanent impairment in diabetes.
Most paitents with age related macular degeneration (ARMD) have the “dry” form. In dry ARMD, note that the bottom layer of the retina (RPE) can become very bumpy and irregular, unlike the “normal” macula above where the RPE is smooth and even.
“Wet” ARMD occurs when a new blood vessel formation (or “neovascular membrane”) invades the retina from the choroid, the layer deep to the retina. This is the type of ARMD that is typically most devastating to vision. Prompt referral to a vitreo-retinal specialist for treatment is required in order to preserve vision.
OCT technology also can analyze the optic nerve and retinal nerve fiber layer to look for structural damage related to glaucoma.